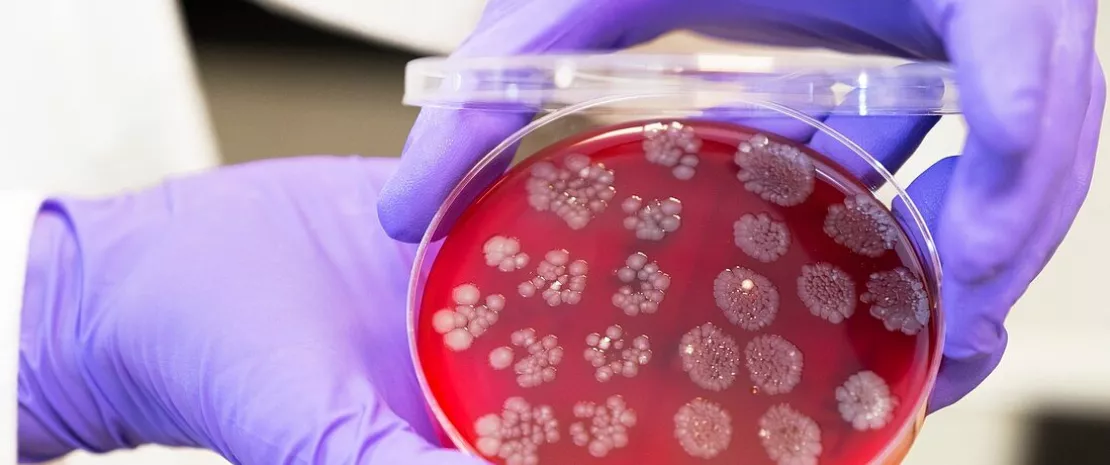

Une véritable révolution dans le contrôle des infections: rôle de la TMF dans la lutte contre les bactéries multi-résistantes chez les patients transplantés
Une étude pivot révèle que la transplantation de microbiote fécal (TMF) constitue une stratégie efficace contre les bactéries multi-résistantes (BMR) chez les transplantés rénaux, marquant ainsi une avancée importante dans le contrôle des infections et de la résistance aux antimicrobiens.
en_sources_title
en_sources_text_start en_sources_text_end
A propos de cet article
Auteur
L’apparition de bactéries multi-résistantes (BMR) pose un formidable défi de santé publique, notamment chez les patients immunodéprimés, y compris las transplantés rénaux. Un récent essai contrôlé randomisé a braqué les projecteurs sur la transplantation de microbiote fécal (TMF) en tant qu’intervention prometteuse pour réduire la colonisation par les BMR chez cette population vulnérable. L'essai a comporté une évaluation méticuleuse de la sécurité et de l’efficacité de la FMT, ainsi que de la dynamique d’élimination des souches de BMR, avec des résultats impressionnants.
Efficacité de l’élimination et de la prise de greffe
L’étude a été menée à l’Hôpital Universitaire Emory d’Atlanta, aux États-Unis, avec une randomisation 1:1 de onze transplantés rénaux entre un groupe TMF (n= 6) et un groupe d’observation (n= 5). Tous les participants qui restaient positifs aux BMR après la première intervention (J36) ont ensuite reçu une TMF, indépendamment de leur affectation initiale, afin d’évaluer plus en détail l’efficacité de la TMF et sa capacité à éliminer les souches bactériennes résistantes.
L’étude a permis d’observer un taux de réussite impressionnant, puisque 8 des 9 patients ayant reçu tous les traitements spécifiés dans le protocole étaient négatifs aux BMR après la TMF. Ce succès a été attribué à la transplantation réussie de taxons bénéfiques du donneur, notamment Akkermansia muciniphila et Faecalibacterium prausnitzii, dans le microbiote intestinal des receveurs. Ces taxons sont connus pour leur rôle bénéfique dans l’intestin humain, ce qui suggère une approche ciblée pour renforcer le microbiote du receveur contre la colonisation par les BMR.
Un déplacement plutôt qu’un remplacement
Afin d’approfondir la question essentielle du déplacement des souches de BMR, l’étude a inclus une analyse détaillée qui a mis en lumière le rôle crucial joué par l’introduction de souches bactériennes compétitives et conspécifiques provenant du donneur. Ce processus, loin d’être un simple remplacement, est un authentique déplacement stratégique profitant de la concurrence microbienne au sein du microbiote intestinal. Les chercheurs ont méticuleusement examiné les différences de contenu génétique entre les souches présentes initialement et les souches de remplacement pour certains groupes d’isolats conspécifiques, en se concentrant sur les gènes susceptibles de renforcer la concurrence entre les souches ou leur adhésion à la surface des cellules hôtes.
L’analyse du contenu génétique a produit des résultats importants, notamment en ce qui concerne les colicines, un sous-ensemble de bactériocines produites par E. coli qui sont toxiques pour d’autres souches d’E. coli et certaines souches apparentées. Les résultats expérimentaux montrent que les souches d’E. coli productrices de colicine peuvent supplanter les souches sensibles à la colicine qui, à leur tour, peuvent être supplantées par des souches résistantes à la colicine, ce qui démontre l’existence d’une dynamique de compétition complexe et non transitive que l’on pourrait comparer à celle du jeu de pierre, papier, ciseaux. L’étude a clairement démontré l’existence de cette dynamique puisque les souches de remplacement sensibles possédaient de multiples gènes de colicine et d’immunité à la colicine qui étaient absents dans les souches résistantes aux antibiotiques.
Ces résultats illustrent les multiples facettes de l’impact de la TMF sur l’écologie microbienne intestinale, soulignant que le déplacement des BMR par la TMF est un processus complexe dans lequel interviennent la compétition microbienne, les déterminants génétiques de la compétitivité et les pressions sélectives de l’environnement intestinal.
Implications pour la pratique clinique
Les implications de cette étude vont bien au-delà des effets bénéfiques immédiats pour les transplantés rénaux. En effet, elle marque un changement de paradigme dans la façon d’aborder le contrôle des infections et la résistance aux antimicrobiens, en préconisant des traitements innovants mettant à contribution les communautés microbiennes naturelles de l’organisme. Au fur et à mesure des progrès accomplis, l’intégration de la TMF dans la pratique clinique pourrait révolutionner la prise en charge de la colonisation par les BMR, offrant ainsi de l’espoir aux patients et aux soignants.